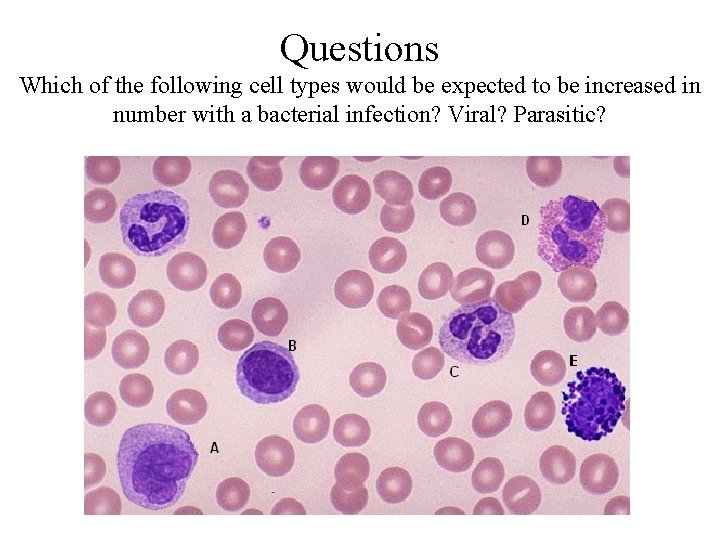
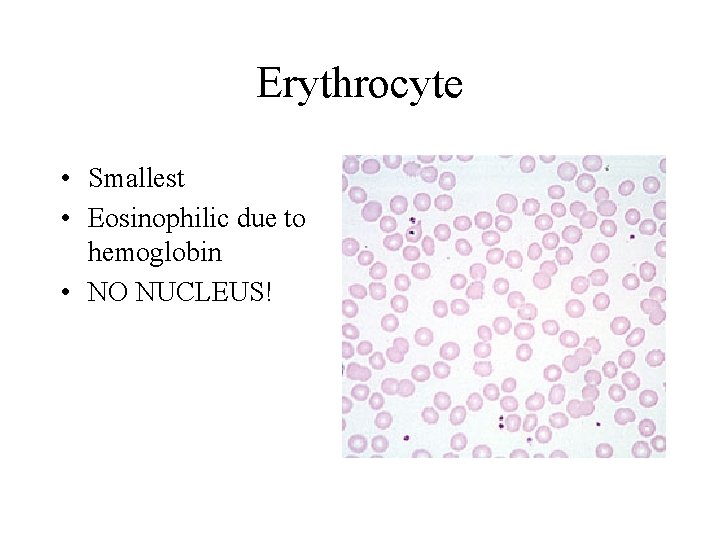
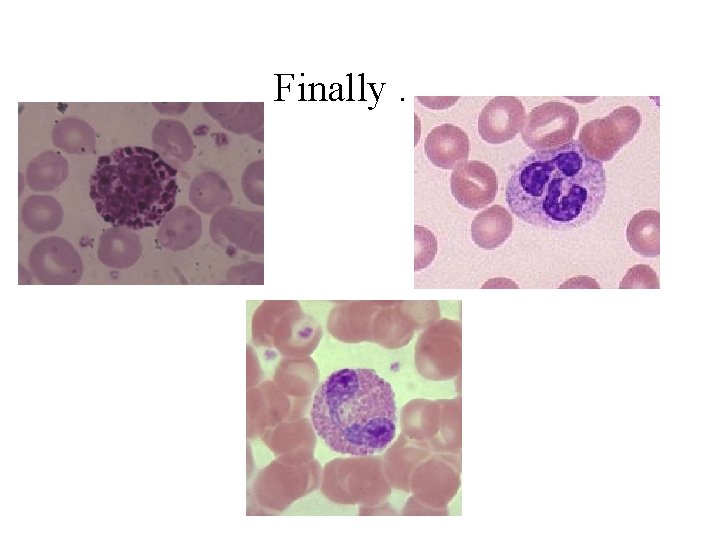

Bone Marrow Hemopoiesis Presented by Dr Salwa Abdel

Bone Marrow &Hemopoiesis Presented by Dr. Salwa Abdel Raouf

ILOs By the end this chapter the student should be able to: - Describe the structure of red blood corpuscles (RBCs) - Classify the WBCS into granular &nongranular - Discuss the L/M &E/M structure & function of WBCS &platelets - Describe the histological picture of the bone marrow - Describe stages of erythropoiesis

Formed Elements of the Blood

Peripheral Blood: Erythrocytes • RBCs constitute the largest number of cells in the blood • Biconcave discs • NO NUCLEUS • Contain Hemoglobin

Peripheral Blood: Platelets • Derived from Megakaryocytes in bone marrow – formed from small bits of Megakaryocyte cytoplasm • Function in blood clotting

Peripheral Blood: Leukocytes • GRANULOCYTES – Neutrophils – Basophils – Eosinophils • AGRANULOCYTES – Lymphocytes (T and B cells) – Monocytes (Macrophages)

Peripheral Blood: Leukocytes • GRANULOCYTES – Neutrophils – Basophils – Eosinophils

Granulocytes: Neutrophils • Most numerous WBC in blood • Multilobed nucleus • Granules: – Azurophilic granules – Specific granules • Function – 1 st wave of cells in acute inflammation; can phagocytose bacteria

Granulocytes: Basophils • Rare! • Lobulated nucleus often obscured by granules • Dark Blue Granules – Hydrolytic enzymes, heparin sulfate, histamine, SRS • Function – Role in hypersensitivity and anaphylaxis

Granulocytes: Eosinophils • Bilobed nucleus • Bright pink Granules – major basic protein, histaminase& sulfatase • Function: – Important in allergic reactions, parasitic infections, and phagocytosis of Ab-Ag complexes

Agranulocytes: Monocytes • Largest WBCs in blood smear • Migrate through blood to the tissues; once in tissues they differentiate into phagocytes (macrophages)

Agranulocytes: Lymphocytes • About size of RBCs • Function – Main functional cells of adaptive immune system - T cells - B cells - Null cells
Questions Which of the following cell types would be expected to be increased in number with a bacterial infection? Viral? Parasitic?

Hemopoiesis Blood Cell Formation (Red marrow)

Diagram of bone marrow Blood flow through marrow: Gray’s Anatomy Source Undetermined Marrow sinuses are sinusoidal, discontinuous capillaries. Mature cells enter the sinuses and are conveyed to the systemic circulation via nutrient veins.

bone marrow Hemocytoblasts: One type of stem cell for all blood cells. . . then differentiation into 5 types of progenitor stem cells: Erythroblast Myeloblast Monoblast Megakaryoblast Lymphoblast

Function of bone marrow -Hemopoiesis = Blood Cell Formation(Red marrow) -Production - hormonal influence -Bone marrow may store up 10 - 20 times more WBC's than in blood


CFU-GEMM CFU-E CFU-Mk CFU-M Trombopoiesis Monopoiesis CFU-G Granulopoiesis (neutrophils, eosinophils basophils) Erythropoiesis

RBC Development


Proerythroblast • Biggest in line age • Large central nucleus with one or two nucleoli • Deep basophilic cytoplasm due to ribosomes • Look for Golgi ghost

Basophilic Erythroblast • Smaller than proerythroblast • Heterochromatic nucleus) • Intense basophilia (lots of ribosomes!)

Proerythroblast Basophilic Erythroblast

Polychromatophilic Erythroblast • Smaller than basophilic erythroblast • Smaller intensely heterochromatic nucleus • Purple/lilac cytoplasm mix of basophilia from ribosomes and growing eosinophilia from hemoglobin • LAST MITOTIC STAGE!

Normoblast • Smaller than polychromatophilic erythroblast • Small, compact, intensely staining nucleus that is getting ready to be extruded • Eosinophilic cytoplasm due to abundant hemoglobin

Reticulocyte • Immature RBC that has polyribosomes • Appear as polychromatophilic erythrocyte on blood smear when stained with a special (supravital stain) (Brilliant cresyl blue).
Erythrocyte • Smallest • Eosinophilic due to hemoglobin • NO NUCLEUS!

What are the Granulocytes? These are cells of the immune system (White Blood Cells) that contain vesicles. The vesicle contents vary among cell lines and stain differently. • Neutrophils (polymorphonuclear or PMN cells) • Eosinophils • Basophils

Development of Granulocytes



Trend of Development of WBCs • • Larger to smaller Azure granules to specific granules Round nucleus to altered shape nucleus Granulocyte Line age: Myeloblast → Promyelocyte → Metamyelocyte → Band cell → Granulocyte

Trend of Development • • Larger to smaller Azure granules to specific granules Round nucleus to altered shape nucleus Granulocyte Line age: Myeloblast → Promyelocyte → Metamyelocyte → Band → Granulocyte NB (Erythroid: Proerythroblast →Basophilic erythroblast → Polychromatophilic → erythroblast → Normoblast → Reticulocyte → Erythrocyte)

Development of Granulocytes

Myeloblast Prominent nucleoli

Promyelocyte • Details • -Golgi ghost • -Can’t distinguish type of • granulocyte yet • -Eccentric nucleus • • • Don’t confuse with proerythroblast or basophilic erythroblasts(smaller-no granules)

Myelocyte • Last stage in which mitosis can occur • Begin to see which’s a neutrophil, which’s an eosinophil &which’s a basophil. • Golgi ghost

Neutrophilic Myelocyte Eosinophilic Myelocyte

Metamyelocyte • nucleus changing shape, not spherical • So. . . No more mitosis

Band Cell • Immature granulocyte • Elongated nucleus of nearly uniform width; horseshoe/U-shaped
Finally. . .

Myeloblast – no granules capable of mitosis Promyelocyte – azurophilic granules Mylocyte – specific granules Metamylocyte – specifc granules nucleus changes shape Band cell – (PMN only) specific granules Mature Granulocyte – specific granules

Compare what you see. . . Myeloblast Pro myelocyte proerythroblast Proerythroblast

Megakaryocyte • Huge cells • Platelets are formed from invaginations of this platelet demarcation channels, membrane-bound spaces forming the boundaries between future platelets. • Multilobular nucleus

Megakaryocyte • Huge cells • Platelets form from invaginations of this platelet demarcation channels, membranebound spaces forming the boundaries between future platelets. • Multilobular nucleus


Trend of Development of WBCs • • Larger to smaller Azure granules to specific granules Round nucleus to altered shape nucleus Granulocyte Line age: Myeloblast → Promyelocyte → Metamyelocyte → Band cell → Granulocyte

Don’t Worry, Be Happy!
- Slides: 49